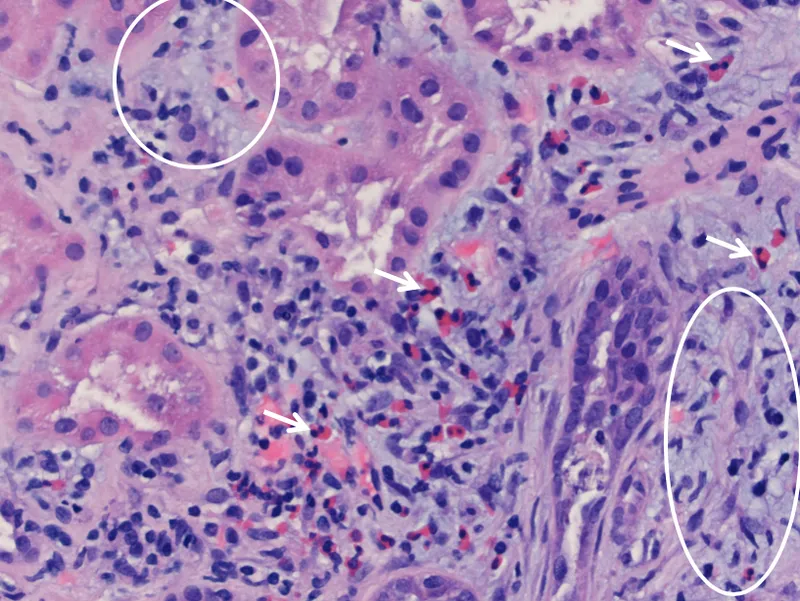
Acute interstitial nephritis with eosinophilic infiltrate

Acute Tubular Injury - Tube Shock Central
- Most common cause of Acute Kidney Injury (AKI); reversible damage to tubular epithelial cells.
- Etiology:
- Ischemic (80%): Hypotension (shock), hypovolemia, sepsis. 📌 "Tube Shock Central".
- Nephrotoxic (20%): Aminoglycosides, contrast, heavy metals (Pb, Hg), myoglobin, ethylene glycol.
- Pathogenesis:
- Ischemia → ↓ATP → cell injury/necrosis → tubular obstruction (casts) & backleak.
- Nephrotoxins → direct tubular cell damage.
- Phases:
- Initiation (hours-days): Insult; ↓urine output, ↑BUN, ↑Cr.
- Maintenance (1-3 weeks): Sustained ↓GFR. Oliguria (<400 mL/day), uremia, hyperkalemia, metabolic acidosis.
- Recovery: Tubular regeneration; polyuria (risk of hypokalemia); GFR gradually normalizes.
- Morphology:
- Proximal convoluted tubules (PCT) & thick ascending limb (TAL) most vulnerable.
- Loss of brush border, epithelial cell sloughing, tubular dilatation.
- Interstitial edema.

⭐ Muddy brown granular casts in urine sediment are pathognomonic for ATN.
Acute Interstitial Nephritis - Allergic Kidney Attack
- Inflammatory infiltrate & edema in renal interstitium; tubules affected (tubulitis).
- Etiology:
- Drugs (Most common, >70%): Penicillins, NSAIDs, PPIs, Sulfonamides, Rifampicin. (📌 Think "P-DRUGS": PPIs, Penicillins, Painkillers (NSAIDs), Diuretics, Rifampicin, SUlfonamides)
- Infections: Bacterial, Viral (CMV, EBV).
- Systemic: Sarcoidosis, SLE, TINU syndrome.
- Classic Triad (often incomplete, <10-30%): Fever, Rash, Eosinophilia.
- Other: Arthralgia, AKI features (oliguria, ↑Cr).
- Urinalysis: Eosinophiluria (Hansel/Wright stain), WBCs, WBC casts, sterile pyuria, mild proteinuria.
- Biopsy: Interstitial edema & cellular infiltrate (lymphocytes, eosinophils); tubulitis.
- Management: Withdraw offending agent; Corticosteroids if severe/persistent.
⭐ NSAID-induced AIN can present with heavy proteinuria and features of minimal change disease, unlike typical drug-induced AIN where proteinuria is usually mild to moderate and glomerular changes are absent or minimal beyond foot process effacement in some cases of NSAID AIN.
Chronic Tubulointerstitial Nephritis & Pyelonephritis - Kidney's Long Haul
- Chronic Tubulointerstitial Nephritis (CTIN): Persistent inflammation & fibrosis of renal tubules/interstitium, leading to chronic kidney disease.
- Causes: Drugs (analgesics - phenacetin, NSAIDs; lithium), toxins (lead), metabolic (hypercalcemia, hypokalemia), immune (Sjogren's), infections, obstruction.
- Patho: Interstitial fibrosis, tubular atrophy, mononuclear infiltrates. Often non-specific.
- Features: Gradual ↓GFR, polyuria, nocturia (impaired concentrating ability), HTN, anemia. Sterile pyuria common.
- Analgesic Nephropathy: Classic cause; papillary necrosis, cortical scarring. Risk: >1g/day phenacetin for >3yrs.
- Chronic Pyelonephritis (CPN): Tubulointerstitial scarring from recurrent/persistent bacterial infection.
- Key Associations: Vesicoureteral reflux (VUR) in children, chronic obstruction in adults.
- Patho: Coarse, asymmetric renal scars, typically polar; blunted/deformed calyces.
- Micro: "Thyroidization" of tubules (colloid-like casts).
- Features: Insidious onset; may present with HTN, recurrent UTIs, flank pain, or progressive renal insufficiency.
⭐ Thyroidization of tubules (dilated tubules with eosinophilic casts resembling thyroid follicles) is a characteristic histological feature of chronic pyelonephritis.

High‑Yield Points - ⚡ Biggest Takeaways
- Acute Tubular Necrosis (ATN): Most common AKI cause; muddy brown casts are key.
- Acute Interstitial Nephritis (AIN): Often drug-induced (e.g., NSAIDs, penicillins); classic triad: fever, rash, eosinophilia.
- Pyelonephritis: WBC casts indicate renal infection; E. coli is the most common pathogen.
- Analgesic nephropathy: Chronic use leads to papillary necrosis and chronic interstitial nephritis.
- Myeloma Kidney: Light chain casts (Bence Jones proteins) are directly toxic to renal tubules.
- Chronic pyelonephritis: Shows cortical scars and thyroidization of tubules; often due to reflux nephropathy or obstruction.
- Renal Tubular Acidosis (RTA): Suspect with normal anion gap metabolic acidosis; Type 1 (distal) has impaired H+ secretion, Type 2 (proximal) has impaired HCO3- reabsorption, Type 4 involves aldosterone deficiency/resistance causing hyperkalemia.
Unlock the full lesson and continue reading
Signup to continue reading this lesson and unlimited access questions, flashcards, AI notes, and more